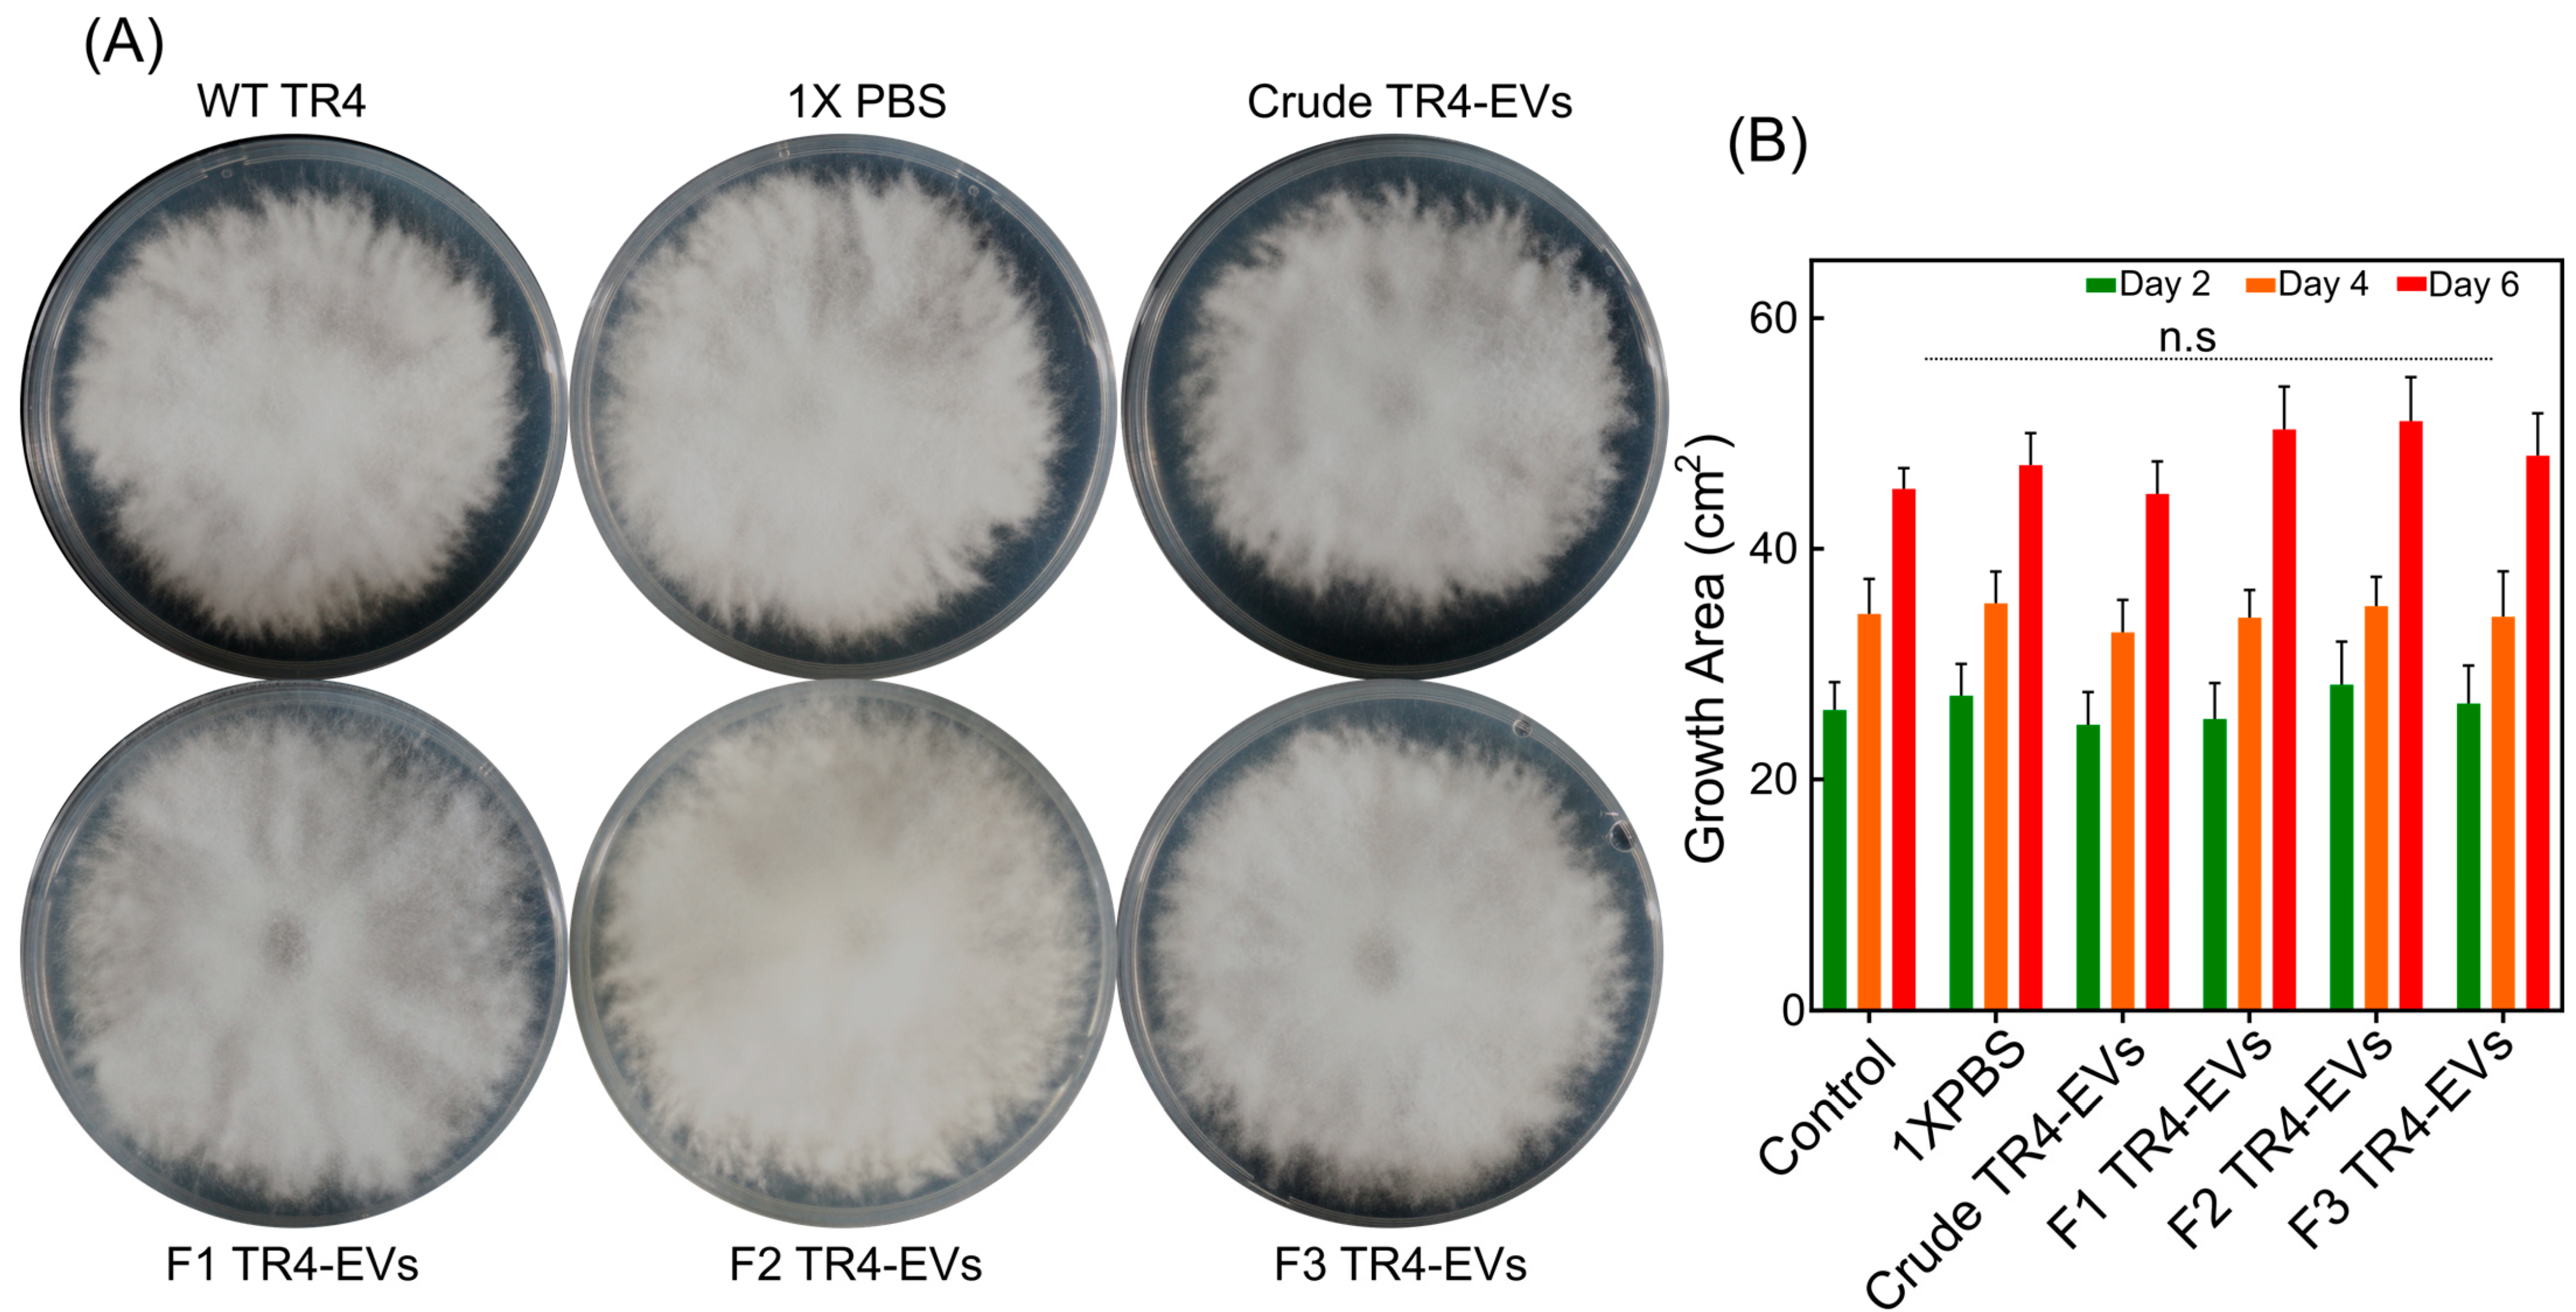
Plants 13 03534 g004

Isolation, Characterization, and Proteomic Analysis of Crude and Purified Extracellular Vesicles Extracted from Fusarium oxysporum f. sp. cubense
Abstract
1. Introduction
2. Materials and Methods
2.1. Foc TR4 Culture Growth
2.2. Isolation and Gradient Purification of Foc TR4 EVs from Culture Media
2.3. Transmission Electron Microscopy (TEM)
2.4. Nanoparticle Tracking Analysis (NTA)
2.5. Bicinchoninic Acid Assay (BCA)
2.6. Sodium Dodecyl Sulfate-Polyacrylamide Gel Electrophoresis (SDS-PAGE)
2.7. Leaf Phytotoxicity Assay
2.8. RNA Extraction and qRT-PCR
2.9. Biocontrol Effects of EVs on Spores of Foc TR4
2.10. LC-MS/MS
2.11. Proteome Identification and Quantification
2.12. Data Analysis
3. Results
3.1. Isolation and Characterization of TR4-EVs by TEM and NTA
3.2. Protein Concentration and Profile of TR4-EVs by BCA and SDS-PAGE
3.3. Pathogenic Effects of Gradient and Crude EVs on Banana Leaves and Host Immune Response
3.4. Biocontrol Effect of TR4 Gradient and Crude EVs on Spore Germination
3.5. Distinct Proteomic Profiles and Functional Enrichment in Fraction 2 and Crude EVs
4. Discussion
4.1. Ensuring EV Isolation by Gradient Purification Is Necessary
4.2. Gradient-Purified Fraction 2 Carries Superior Abundance, Size, and Purity of Foc TR4 EVs
4.3. Fraction 2 Has Superior Protein Content and Unique Proteomic Profiles
4.4. Crude EVs Exhibit Enhanced Pathogenicity Due to Both EV and Non-EV-Containing Proteins
4.5. Fraction 2 Shows EV-Specific Functions, While Crude EVs Reflect Non-EV Unique Proteins
5. Conclusions
Supplementary Materials
Author Contributions
Funding
Data Availability Statement
Acknowledgments
Conflicts of Interest
References
- Kema, G.H.; Drenth, A.; Dita, M.; Jansen, K.; Vellema, S.; Stoorvogel, J.J. Fusarium Wilt of Banana, a Recurring Threat to Global Banana Production; Frontiers Media SA: Lausanne, Switzerland, 2021; Volume 11, p. 628888. [Google Scholar]
- Ploetz, R.C. Fusarium wilt of banana. Phytopathology 2015, 105, 1512–1521. [Google Scholar] [CrossRef] [PubMed]
- Ma, W.; Zheng, H.; Yuan, P. Impacts of cooperative membership on banana yield and risk exposure: Insights from China. J. Agric. Econ. 2022, 73, 564–579. [Google Scholar] [CrossRef]
- Dong, H.; Ye, Y.; Guo, Y.; Li, H. Comparative transcriptome analysis revealed resistance differences of Cavendish bananas to Fusarium oxysporum f. sp. cubense race1 and race4. BMC Genet. 2020, 21, 122. [Google Scholar]
- Janbon, G.; Rodrigues, M.L. Fungal Extracellular Vesicles: Biological Roles; Springer: Berlin/Heidelberg, Germany, 2021. [Google Scholar]
- Herkert, P.F.; Amatuzzi, R.F.; Alves, L.R.; Rodrigues, M.L. Extracellular vesicles as vehicles for the delivery of biologically active fungal molecules. Curr. Protein Pept. Sci. 2019, 20, 1027–1036. [Google Scholar] [CrossRef]
- Cai, Q.; Qiao, L.; Wang, M.; He, B.; Lin, F.-M.; Palmquist, J.; Huang, S.-D.; Jin, H. Plants send small RNAs in extracellular vesicles to fungal pathogen to silence virulence genes. Science 2018, 360, 1126–1129. [Google Scholar] [CrossRef]
- Liebana-Jordan, M.; Brotons, B.; Falcon-Perez, J.M.; Gonzalez, E. Extracellular vesicles in the fungi kingdom. Int. J. Mol. Sci. 2021, 22, 7221. [Google Scholar] [CrossRef]
- Rutter, B.D.; Chu, T.T.H.; Dallery, J.F.; Zajt, K.K.; O’Connell, R.J.; Innes, R.W. The development of extracellular vesicle markers for the fungal phytopathogen Colletotrichum higginsianum. J. Extracell. Vesicles 2022, 11, e12216. [Google Scholar] [CrossRef]
- Bleackley, M.R.; Samuel, M.; Garcia-Ceron, D.; McKenna, J.A.; Lowe, R.G.; Pathan, M.; Zhao, K.; Ang, C.-S.; Mathivanan, S.; Anderson, M.A. Extracellular vesicles from the cotton pathogen Fusarium oxysporum f. sp. vasinfectum induce a phytotoxic response in plants. Front. Plant Sci. 2020, 10, 1610. [Google Scholar] [CrossRef] [PubMed]
- Kwon, S.; Rupp, O.; Brachmann, A.; Blum, C.F.; Kraege, A.; Goesmann, A.; Feldbrügge, M. mRNA inventory of extracellular vesicles from Ustilago maydis. J. Fungi 2021, 7, 562. [Google Scholar] [CrossRef]
- Garcia-Ceron, D.; Lowe, R.G.; McKenna, J.A.; Brain, L.M.; Dawson, C.S.; Clark, B.; Berkowitz, O.; Faou, P.; Whelan, J.; Bleackley, M.R. Extracellular vesicles from Fusarium graminearum contain protein effectors expressed during infection of corn. J. Fungi 2021, 7, 977. [Google Scholar] [CrossRef]
- Costa, J.H.; Bazioli, J.M.; Barbosa, L.D.; dos Santos Júnior, P.L.T.; Reis, F.C.; Klimeck, T.; Crnkovic, C.M.; Berlinck, R.G.; Sussulini, A.; Rodrigues, M.L. Phytotoxic tryptoquialanines produced in vivo by Penicillium digitatum are exported in extracellular vesicles. mBio 2021, 12, e03393-20. [Google Scholar] [CrossRef] [PubMed]
- Hill, E.H.; Solomon, P.S. Extracellular vesicles from the apoplastic fungal wheat pathogen Zymoseptoria tritici. Fungal Biol. Biotechnol. 2020, 7, 13. [Google Scholar] [CrossRef] [PubMed]
- Thieron, H.S. Characteristics, Dynamics, and Potential Cargos of Hordeum Vulgare Mesophyll Extracellular Vesicles in the Context of Infection with Its Powdery Mildew Fungus Blumeria hordei. Ph.D. Dissertation, RWTH Aachen University, Aachen, Germany, 2022. [Google Scholar]
- Vagner, T.; Chin, A.; Mariscal, J.; Bannykh, S.; Engman, D.M.; Di Vizio, D. Protein composition reflects extracellular vesicle heterogeneity. Proteomics 2019, 19, 1800167. [Google Scholar] [CrossRef]
- Kowal, J.; Arras, G.; Colombo, M.; Jouve, M.; Morath, J.P.; Primdal-Bengtson, B.; Dingli, F.; Loew, D.; Tkach, M.; Théry, C. Proteomic comparison defines novel markers to characterize heterogeneous populations of extracellular vesicle subtypes. Proc. Natl. Acad. Sci. USA 2016, 113, E968–E977. [Google Scholar] [CrossRef]
- Théry, C.; Witwer, K.W.; Aikawa, E.; Alcaraz, M.J.; Anderson, J.D.; Andriantsitohaina, R.; Antoniou, A.; Arab, T.; Archer, F.; Atkin-Smith, G.K. Minimal information for studies of extracellular vesicles 2018 (MISEV2018): A position statement of the International Society for Extracellular Vesicles and update of the MISEV2014 guidelines. J. Extracell. Vesicles 2018, 7, 1535750. [Google Scholar] [CrossRef]
- Carnino, J.M.; Lee, H.; Jin, Y. Isolation and characterization of extracellular vesicles from Broncho-alveolar lavage fluid: A review and comparison of different methods. Respir. Res. 2019, 20, 240. [Google Scholar] [CrossRef]
- De Sousa, K.P.; Rossi, I.; Abdullahi, M.; Ramirez, M.I.; Stratton, D.; Inal, J.M. Isolation and characterization of extracellular vesicles and future directions in diagnosis and therapy. Wiley Interdiscip. Rev. Nanomed. Nanobiotechnol. 2023, 15, e1835. [Google Scholar] [CrossRef]
- Anuar, N.F.Z.; Desa, M.N.M.; Hussaini, J.; Wong, E.H.; Mariappan, V.; Vellasamy, K.M.; Kumari, N. Extraction of Extracellular Membrane Vesicles (EMV) from Streptococcus pneumoniae using Ultracentrifugation, Ultrafiltration and Iodixanol Gradient Fractionation. Curr. Trends Biotechnol. Pharm. 2023, 17 (Suppl. S4A), 108–113. [Google Scholar] [CrossRef]
- Cvjetkovic, A.; Lötvall, J.; Lässer, C. The influence of rotor type and centrifugation time on the yield and purity of extracellular vesicles. J. Extracell. Vesicles 2014, 3, 23111. [Google Scholar] [CrossRef] [PubMed]
- Ramirez, M.I.; Amorim, M.G.; Gadelha, C.; Milic, I.; Welsh, J.A.; Freitas, V.M.; Nawaz, M.; Akbar, N.; Couch, Y.; Makin, L. Technical challenges of working with extracellular vesicles. Nanoscale 2018, 10, 881–906. [Google Scholar] [CrossRef] [PubMed]
- Zhan, N.; Kuang, M.; He, W.; Deng, G.; Liu, S.; Li, C.; Roux, N.; Dita, M.; Yi, G.; Sheng, O. Evaluation of Resistance of Banana Genotypes with AAB Genome to Fusarium Wilt Tropical Race 4 in China. J. Fungi 2022, 8, 1274. [Google Scholar] [CrossRef]
- Michielse, C.B.; Rep, M. Pathogen profile update: Fusarium oxysporum. Mol. Plant Pathol. 2009, 10, 311. [Google Scholar] [CrossRef] [PubMed]
- Fleming, A.; Sampey, G.; Chung, M.C.; Bailey, C.; Van Hoek, M.L.; Kashanchi, F.; Hakami, R.M. The carrying pigeons of the cell: Exosomes and their role in infectious diseases caused by human pathogens. Pathog. Dis. 2014, 71, 109–120. [Google Scholar] [CrossRef] [PubMed]
- Liu, S.; Wu, B.; Yang, J.; Bi, F.; Dong, T.; Yang, Q.; Hu, C.; Xiang, D.; Chen, H.; Huang, H. A cerato-platanin family protein FocCP1 is essential for the penetration and virulence of Fusarium oxysporum f. sp. cubense tropical race 4. Int. J. Mol. Sci. 2019, 20, 3785. [Google Scholar] [CrossRef] [PubMed]
- Ahmad, M.; Li, J.; Yang, Q.; Jamil, W.; Teng, Y.; Bai, S. Phylogenetic, Molecular, and Functional Characterization of PpyCBF Proteins in Asian Pears (Pyrus pyrifolia). Int. J. Mol. Sci. 2019, 20, 2074. [Google Scholar] [CrossRef]
- Černoša, A.; Gostinčar, C.; Lavrin, T.; Kostanjšek, R.; Lenassi, M.; Gunde-Cimerman, N. Isolation and characterization of extracellular vesicles from biotechnologically important fungus Aureobasidium pullulans. Fungal Biol. Biotechnol. 2022, 9, 16. [Google Scholar] [CrossRef] [PubMed]
- Chen, C.; Chen, H.; Zhang, Y.; Thomas, H.R.; Frank, M.H.; He, Y.; Xia, R. TBtools: An integrative toolkit developed for interactive analyses of big biological data. Mol. Plant 2020, 13, 1194–1202. [Google Scholar] [CrossRef]
- Love, M.I.; Huber, W.; Anders, S. Moderated estimation of fold change and dispersion for RNA-seq data with DESeq2. Genome Biol. 2014, 15, 550. [Google Scholar] [CrossRef] [PubMed]
- Lai, Y.; Jiang, B.; Hou, F.; Huang, X.; Ling, B.; Lu, H.; Zhong, T.; Huang, J. The emerging role of extracellular vesicles in fungi: A double-edged sword. Front. Microbiol. 2023, 14, 1216895. [Google Scholar] [CrossRef]
- Jnana, A.; Sadiya, S.; Satyamoorthy, K.; Murali, T. Extracellular vesicles in bacterial and fungal diseases–Pathogenesis to diagnostic biomarkers. Virulence 2023, 14, 2180934. [Google Scholar]
- Devereux, Z. Purifying the Purified: Isolation and Characterisation of Extracellular Vesicles from Candida; ResearchSpace: Auckland, New Zealand, 2018. [Google Scholar]
- Kalluri, R.; LeBleu, V.S. The biology, function, and biomedical applications of exosomes. Science 2020, 367, eaau6977. [Google Scholar] [CrossRef] [PubMed]
- Kruse, T.; Schneider, S.; Reger, L.N.; Kampmann, M.; Reif, O.W. A novel approach for enumeration of extracellular vesicles from crude and purified cell culture samples. Eng. Life Sci. 2022, 22, 334–343. [Google Scholar] [CrossRef] [PubMed]
- Tian, Y.; Gong, M.; Hu, Y.; Liu, H.; Zhang, W.; Zhang, M.; Hu, X.; Aubert, D.; Zhu, S.; Wu, L. Quality and efficiency assessment of six extracellular vesicle isolation methods by nano-flow cytometry. J. Extracell. Vesicles 2020, 9, 1697028. [Google Scholar] [CrossRef]
- De Paula, R.G.; Antoniêto, A.C.C.; Nogueira, K.M.V.; Ribeiro, L.F.C.; Rocha, M.C.; Malavazi, I.; Almeida, F.; Silva, R.N. Extracellular vesicles carry cellulases in the industrial fungus Trichoderma reesei. Biotechnol. Biofuels 2019, 12, 146. [Google Scholar] [CrossRef]
- Bitencourt, T.A.; Rezende, C.P.; Quaresemin, N.R.; Moreno, P.; Hatanaka, O.; Rossi, A.; Martinez-Rossi, N.M.; Almeida, F. Extracellular vesicles from the dermatophyte Trichophyton interdigitale modulate macrophage and keratinocyte functions. Front. Immunol. 2018, 9, 2343. [Google Scholar] [CrossRef] [PubMed]
- Clos-Sansalvador, M.; Monguió-Tortajada, M.; Roura, S.; Franquesa, M.; Borràs, F.E. Commonly used methods for extracellular vesicles’ enrichment: Implications in downstream analyses and use. Eur. J. Cell Biol. 2022, 101, 151227. [Google Scholar] [CrossRef] [PubMed]
- Zamith-Miranda, D.; Heyman, H.M.; Couvillion, S.P.; Cordero, R.J.; Rodrigues, M.L.; Nimrichter, L.; Casadevall, A.; Amatuzzi, R.F.; Alves, L.R.; Nakayasu, E.S. Comparative molecular and immunoregulatory analysis of extracellular vesicles from Candida albicans and Candida auris. mSystems 2021, 6, e00822-21. [Google Scholar] [CrossRef] [PubMed]
- Rodrigues, M.L.; Nakayasu, E.S.; Oliveira, D.L.; Nimrichter, L.; Nosanchuk, J.D.; Almeida, I.C.; Casadevall, A. Extracellular vesicles produced by Cryptococcus neoformans contain protein components associated with virulence. Eukaryot Cell 2008, 7, 58–67. [Google Scholar] [CrossRef]
- Brauer, V.S.; Pessoni, A.M.; Bitencourt, T.A.; de Paula, R.G.; de Oliveira Rocha, L.; Goldman, G.H.; Almeida, F. Extracellular vesicles from Aspergillus flavus induce M1 polarization in vitro. mSphere 2020, 5, e00190-20. [Google Scholar] [CrossRef]
- Zhao, K.; Bleackley, M.; Chisanga, D.; Gangoda, L.; Fonseka, P.; Liem, M.; Kalra, H.; Al Saffar, H.; Keerthikumar, S.; Ang, C.-S. Extracellular vesicles secreted by Saccharomyces cerevisiae are involved in cell wall remodelling. Commun. Biol. 2019, 2, 305. [Google Scholar] [CrossRef] [PubMed]
- Hong, J.; Dauros-Singorenko, P.; Whitcombe, A.; Payne, L.; Blenkiron, C.; Phillips, A.; Swift, S. Analysis of the Escherichia coli extracellular vesicle proteome identifies markers of purity and culture conditions. J. Extracell. Vesicles 2019, 8, 1632099. [Google Scholar] [CrossRef]
- Rizzo, J.; Taheraly, A.; Janbon, G. Structure, composition and biological properties of fungal extracellular vesicles. MicroLife 2021, 2, uqab009. [Google Scholar] [CrossRef] [PubMed]
- Cleare, L.G.; Zamith, D.; Heyman, H.M.; Couvillion, S.P.; Nimrichter, L.; Rodrigues, M.L.; Nakayasu, E.S.; Nosanchuk, J.D. Media matters! Alterations in the loading and release of Histoplasma capsulatum extracellular vesicles in response to different nutritional milieus. Cell. Microbiol. 2020, 22, e13217. [Google Scholar] [CrossRef] [PubMed]
- Escobar-Niño, A.; Harzen, A.; Stolze, S.C.; Nakagami, H.; Fernández-Acero, F.J. The Adaptation of Botrytis cinerea Extracellular Vesicles Proteome to Surrounding Conditions: Revealing New Tools for Its Infection Process. J. Fungi 2023, 9, 872. [Google Scholar] [CrossRef] [PubMed]
- Silva, B.M.; Prados-Rosales, R.; Espadas-Moreno, J.; Wolf, J.M.; Luque-Garcia, J.L.; Gonçalves, T.; Casadevall, A. Characterization of Alternaria infectoria extracellular vesicles. Sabouraudia 2013, 52, 202–210. [Google Scholar] [CrossRef] [PubMed]
- He, B.; Wang, H.; Liu, G.; Chen, A.; Calvo, A.; Cai, Q.; Jin, H. Fungal small RNAs ride in extracellular vesicles to enter plant cells through clathrin-mediated endocytosis. Nat. Commun. 2023, 14, 4383. [Google Scholar] [CrossRef]
- Liu, T.-B.; Xue, C. The ubiquitin-proteasome system and F-box proteins in pathogenic fungi. Mycobiology 2011, 39, 243–248. [Google Scholar] [CrossRef] [PubMed]
- De Vallée, A.; Dupuy, J.-W.; Moriscot, C.; Gallet, B.; Vanderperre, S.; Guignard, G.; Rascle, C.; Calvar, G.; Malbert, B.; Gillet, F.-X. Extracellular vesicles of the plant pathogen Botrytis cinerea. J. Fungi 2023, 9, 495. [Google Scholar] [CrossRef]
- Veerman, R.E.; Teeuwen, L.; Czarnewski, P.; Güclüler Akpinar, G.; Sandberg, A.; Cao, X.; Pernemalm, M.; Orre, L.M.; Gabrielsson, S.; Eldh, M. Molecular evaluation of five different isolation methods for extracellular vesicles reveals different clinical applicability and subcellular origin. J. Extracell. Vesicles 2021, 10, e12128. [Google Scholar] [CrossRef]
- Reymond, S.; Gruaz, L.; Sanchez, J.-C. Depletion of abundant plasma proteins for extracellular vesicle proteome characterization: Benefits and pitfalls. Anal. Bioanal. Chem. 2023, 415, 3177–3187. [Google Scholar] [CrossRef]
- Newman, L.A.; Useckaite, Z.; Rowland, A. Addressing MISEV guidance using targeted LC-MS/MS: A method for the detection and quantification of extracellular vesicle-enriched and contaminant protein markers from blood. J. Extracell. Biol. 2022, 1, e56. [Google Scholar] [CrossRef]

| Pathway | Genes # | Genes Names | Pathogenic Role |
|---|---|---|---|
| F2 TR4-EVs | |||
| Endocytosis | 24 | FOIG_gene0000606; FOIG_gene00745; FOIG_gene00658; FOIG_gene00641; FOIG_gene00616; FOIG_gene00601; FOIG_gene00617; FOIG_gene00682; FOIG_gene00681; FOIG_gene00778; FOIG_gene00787; FOIG_gene00801; FOIG_gene00867; FOIG_gene00977; FOIG_gene01014; FOIG_gene01020; FOIG_gene01027; FOIG_gene01081; FOIG_gene01084; FOIG_gene01101; FOIG_gene01191; FOIG_gene01235; FOIG_gene01285; FOIG_gene01304 | Host cell entry; intracellular trafficking |
|
ABC transporters | 12 | FOIG_gene00710; FOIG_gene00777; FOIG_gene00784; FOIG_gene00805; FOIG_gene00818; FOIG_gene00954; FOIG_gene01076; FOIG_gene01178; FOIG_gene01229; FOIG_gene01247; FOIG_gene01280; FOIG_gene01376 | Transport virulence factors; toxins; nutrients |
| Vesicular transport | 6 | FOIG_gene00650; FOIG_gene00906; FOIG_gene00947; FOIG_gene01082; FOIG_gene01085; FOIG_gene01193 | Transport of virulence factors; facilitate infection |
| MAPK signaling | 24 | FOIG_gene00699; FOIG_gene00709; FOIG_gene00674; FOIG_gene00755; FOIG_gene00640; FOIG_gene00681; FOIG_gene00758; FOIG_gene00785; FOIG_gene00789; FOIG_gene00866; FOIG_gene00919; FOIG_gene00968; FOIG_gene00978; FOIG_gene00991; FOIG_gene01057; FOIG_gene01072; FOIG_gene01089; FOIG_gene01102; FOIG_gene01109; FOIG_gene01113; FOIG_gene01145; FOIG_gene01249; FOIG_gene01361; FOIG_gene01388 | Stress adoptation; virulence regulation |
| Autophagy—yeast | 23 | FOIG_gene00621; FOIG_gene00658; FOIG_gene00723; FOIG_gene00701; FOIG_gene00597; FOIG_gene00601; FOIG_gene00682; FOIG_gene00808; FOIG_gene00825; FOIG_gene00831; FOIG_gene00882; FOIG_gene00924; FOIG_gene00947; FOIG_gene01040; FOIG_gene01084; FOIG_gene01085; FOIG_gene01094; FOIG_gene01145; FOIG_gene01200; FOIG_gene01248; FOIG_gene01257; FOIG_gene01258; FOIG_gene01373 | Cellular survival; immune evasion |
| Proteasome | 14 | FOIG_gene00644; FOIG_gene00740; FOIG_gene00661; FOIG_gene00598; FOIG_gene00680; FOIG_gene00835; FOIG_gene00890; FOIG_gene00958; FOIG_gene00990; FOIG_gene01063; FOIG_gene01087; FOIG_gene01186; FOIG_gene01231; FOIG_gene01341 | Protein degradation; iImmune modulation |
| Lipid metabolism | 10 | FOIG_gene00737; FOIG_gene00611; FOIG_gene00626; FOIG_gene00713; FOIG_gene01043; FOIG_gene00773; FOIG_gene01048; FOIG_gene01227; FOIG_gene01361; FOIG_gene01370 | Membrane composition modulation |
| Common TR4-EVs | |||
| Endocytosis | 21 | FOIG_gene0046; FOIG_gene0072; FOIG_gene0073; FOIG_gene0084; FOIG_gene00119; FOIG_gene00122; FOIG_gene00150; FOIG_gene00172; FOIG_gene00202; FOIG_gene00218; FOIG_gene00221; FOIG_gene00222; FOIG_gene00234; FOIG_gene00243; FOIG_gene00245; FOIG_gene00259; FOIG_gene00352; FOIG_gene00379; FOIG_gene00388; FOIG_gene00463; FOIG_gene00475 | Host colonization; manipulation of host cell machinery |
| ABC transporters | 7 | FOIG_gene0031; FOIG_gene0036; FOIG_gene0089; FOIG_gene00100; FOIG_gene00238; FOIG_gene00458; FOIG_gene00507 | Transportation and fungal adaptation |
| Vesicular transport | 4 | FOIG_gene0085; FOIG_gene00120; FOIG_gene00332; FOIG_gene00467 | Virulence factors secretion |
| MAPK signaling | 17 | FOIG_gene0028; FOIG_gene0075; FOIG_gene00156; FOIG_gene00202; FOIG_gene00207; FOIG_gene00221; FOIG_gene00245; FOIG_gene00250; FOIG_gene00273; FOIG_gene00335; FOIG_gene00352; FOIG_gene00389; FOIG_gene00412; FOIG_gene00471; FOIG_gene00504; FOIG_gene00523; FOIG_gene00544 | Virulence factor production; stress response; host immune defense |
| Autophagy—yeast | 12 | FOIG_gene006; FOIG_gene00150; FOIG_gene00172; FOIG_gene00272; FOIG_gene00274; FOIG_gene00343; FOIG_gene00416; FOIG_gene00453; FOIG_gene00467; FOIG_gene00470; FOIG_gene00472; FOIG_gene00475 | Cellular homeostasis and pathogen survival under stress |
| Proteasome | 3 | FOIG_gene0033; FOIG_gene00167; FOIG_gene00375 | Degradation of host immune factors |
| Glycerophospholipid metabolism | 18 | FOIG_gene0022; FOIG_gene0061; FOIG_gene0071; FOIG_gene0078; FOIG_gene0087; FOIG_gene00114; FOIG_gene00141; FOIG_gene00152; FOIG_gene00159; FOIG_gene00217; FOIG_gene00280; FOIG_gene00325; FOIG_gene00339; FOIG_gene00358; FOIG_gene00405; FOIG_gene00409; FOIG_gene00579; FOIG_gene00580 | Membrane flexibility; fungal adaptability |
| Crude TR4-EVs | |||
| Endocytosis | 2 | FOIG_gene01418; FOIG_gene01495 | Establishment of infection |
| ABC transporters | 6 | FOIG_gene01568; FOIG_gene01402; FOIG_gene01537; FOIG_gene01459; FOIG_gene01537; FOIG_gene01568 | Resistance to antifungal compounds |
| Vesicular transport | 0 | FOIG_gene00650; FOIG_gene00906; FOIG_gene00947; FOIG_gene01082; FOIG_gene01085; FOIG_gene01193 | Secretion of effector proteins |
| MAPK signaling | 2 | FOIG_gene01499; FOIG_gene01569 | Survival; pathogenesis |
| Autophagy—yeast | 1 | FOIG_gene01499 | Cellular integrity |
| Proteasome | 5 | FOIG_gene01405; FOIG_gene01411; FOIG_gene01452; FOIG_gene01470; FOIGgene01505 | Degradation of host proteins |
| Metabolism | 36 | FOIG_gene01426; FOIG_gene01400; FOIG_gene01417; FOIG_gene01404; FOIG_gene01416; FOIG_gene01409; FOIG_gene01429; FOIG_gene01432; FOIG_gene01437; FOIG_gene01450; FOIG_gene01451; FOIG_gene01470; FOIG_gene01478; FOIG_gene01480; FOIG_gene01487; FOIG_gene01491; FOIG_gene01492; FOIG_gene01493; FOIG_gene01500; FOIG_gene01527; FOIG_gene01532; FOIG_gene01535; FOIG_gene01542; FOIG_gene01543; FOIG_gene01545; FOIG_gene01546; FOIG_gene01548; FOIG_gene01554; FOIG_gene01559; FOIG_gene01561; FOIG_gene01562; FOIG_gene01563; FOIG_gene01564; FOIG_gene01566; FOIG_gene01570; FOIG_gene01572 | Fungal growth; survival |
Disclaimer/Publisher’s Note: The statements, opinions and data contained in all publications are solely those of the individual author(s) and contributor(s) and not of MDPI and/or the editor(s). MDPI and/or the editor(s) disclaim responsibility for any injury to people or property resulting from any ideas, methods, instructions or products referred to in the content. |
© 2024 by the authors. Licensee MDPI, Basel, Switzerland. This article is an open access article distributed under the terms and conditions of the Creative Commons Attribution (CC BY) license (https://creativecommons.org/licenses/by/4.0/).
Share and Cite
Ahmad, M.; Liu, Y.; Huang, S.; Huo, Y.; Yi, G.; Liu, C.; Jamil, W.; Yang, X.; Zhang, W.; Li, Y.; et al. Isolation, Characterization, and Proteomic Analysis of Crude and Purified Extracellular Vesicles Extracted from Fusarium oxysporum f. sp. cubense. Plants 2024, 13, 3534. https://doi.org/10.3390/plants13243534
Ahmad M, Liu Y, Huang S, Huo Y, Yi G, Liu C, Jamil W, Yang X, Zhang W, Li Y, et al. Isolation, Characterization, and Proteomic Analysis of Crude and Purified Extracellular Vesicles Extracted from Fusarium oxysporum f. sp. cubense. Plants. 2024; 13(24):3534. https://doi.org/10.3390/plants13243534
Chicago/Turabian StyleAhmad, Mudassar, Yushan Liu, Shiyi Huang, Yile Huo, Ganjun Yi, Chongfei Liu, Wajeeha Jamil, Xiaofang Yang, Wei Zhang, Yuqing Li, and et al. 2024. "Isolation, Characterization, and Proteomic Analysis of Crude and Purified Extracellular Vesicles Extracted from Fusarium oxysporum f. sp. cubense" Plants 13, no. 24: 3534. https://doi.org/10.3390/plants13243534
APA StyleAhmad, M., Liu, Y., Huang, S., Huo, Y., Yi, G., Liu, C., Jamil, W., Yang, X., Zhang, W., Li, Y., Xiang, D., Huoqing, H., Liu, S., Wang, W., & Li, C. (2024). Isolation, Characterization, and Proteomic Analysis of Crude and Purified Extracellular Vesicles Extracted from Fusarium oxysporum f. sp. cubense. Plants, 13(24), 3534. https://doi.org/10.3390/plants13243534






